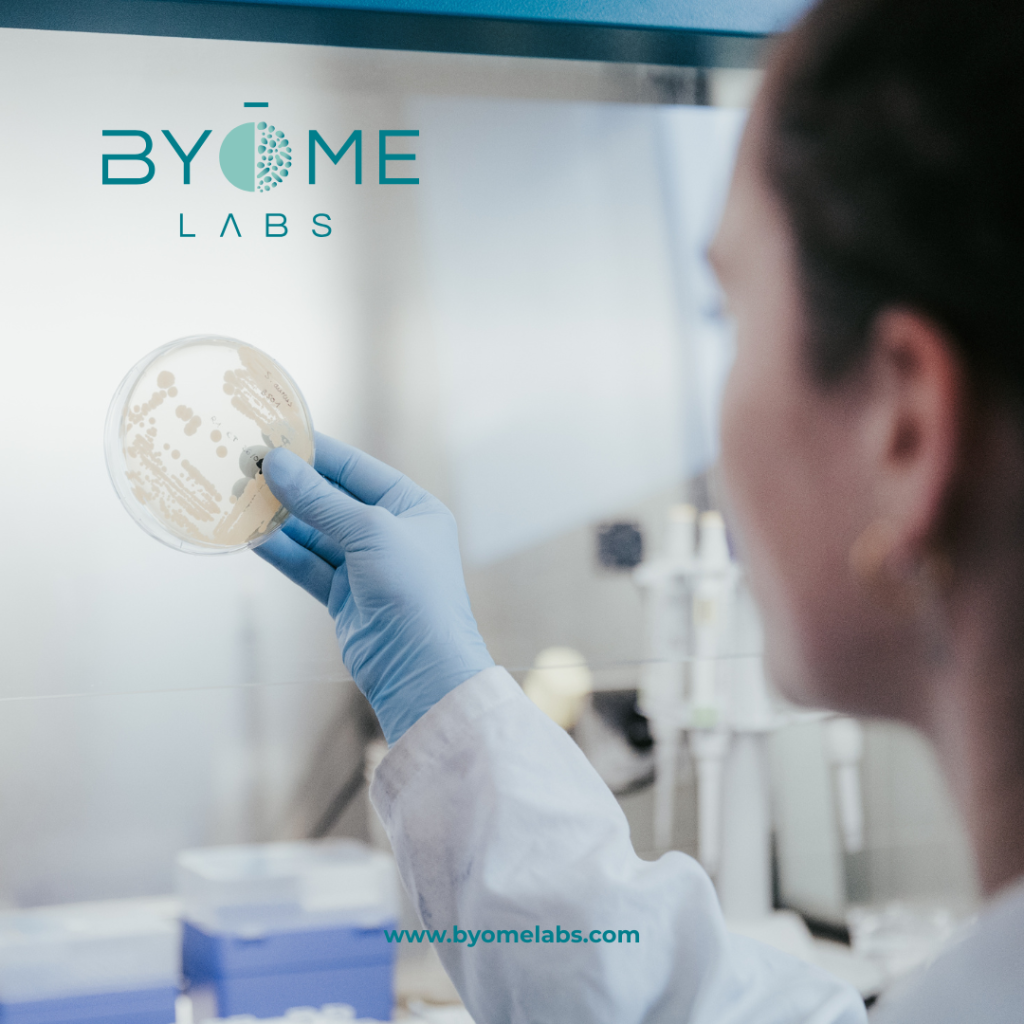
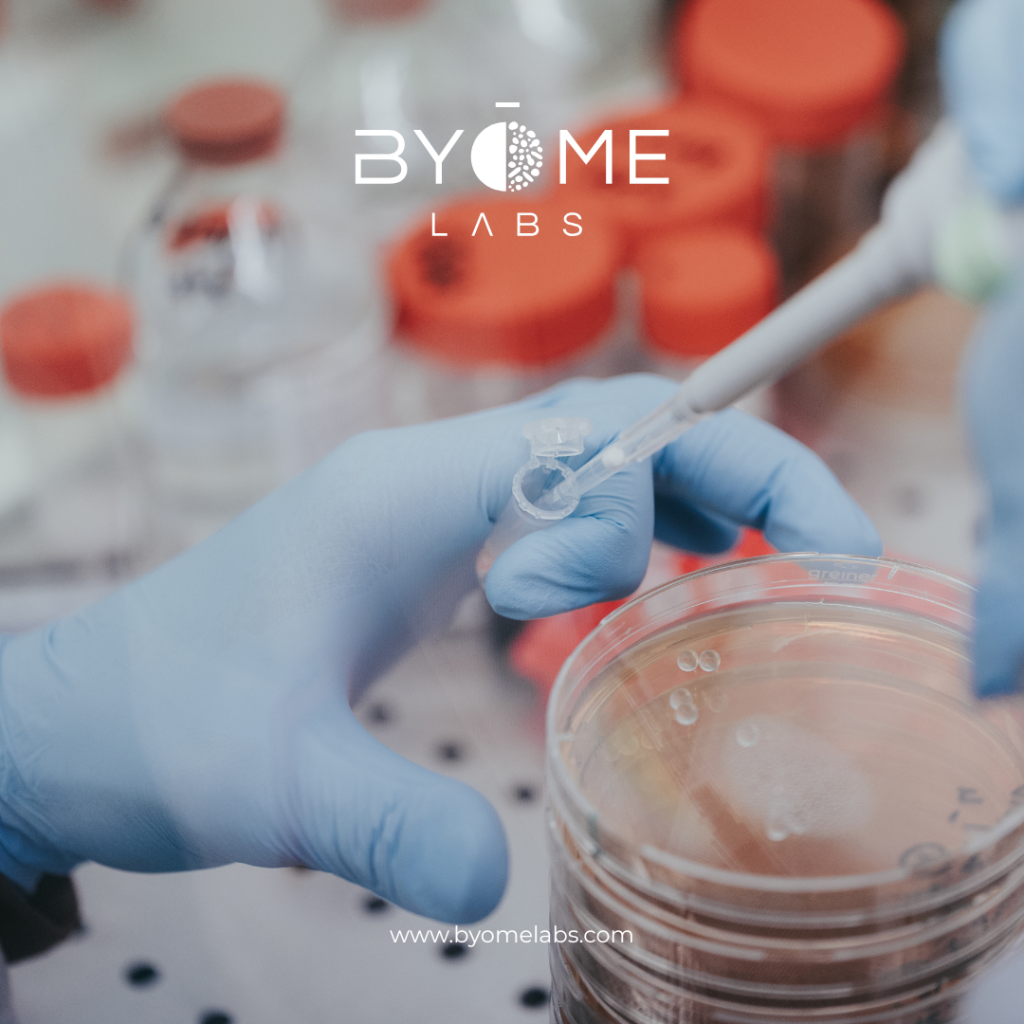

The skin microbiome: a structured ecosystem shaped by its environment
The skin, the largest organ of the human body, hosts a diverse microbial community composed predominantly of commensal microorganisms, often neutral or even beneficial to the host (Grice & Segre, 2011). These symbiotic populations occupy distinct ecological niches and actively contribute to protection against opportunistic microorganisms. Beyond this barrier function, they also engage in dialogue with the cutaneous immune system and play a role in the local regulation of homeostasis (Grice & Segre, 2011).

The composition of the microbiome varies between individuals and across anatomical sites, influenced by factors such as age, sex, and environment. Sebaceous regions are predominantly colonized by lipophilic species of the genus Cutibacterium, moist areas by Staphylococcus and Corynebacterium, while dry surfaces exhibit greater diversity, particularly of Proteobacteria and Bacteroidetes (Suri et al., 2025).
Skin microbiome homeostasis can be disrupted by intrinsic factors, such as aging or certain pathologies, as well as by extrinsic influences. Impairment of the skin barrier may then promote a state of dysbiosis, characterized by reduced microbial diversity and the excessive proliferation of specific species. This imbalance is associated with an increased risk of infections and inflammatory dermatoses such as acne, atopic dermatitis, or psoriasis, as well as impaired wound-healing processes (Borrego-Ruiz & Borrego, 2024; Grice & Segre, 2011).
Cosmetic products: an influence that is rarely neutral
Cosmetic and hygiene products directly modify the skin environment. By influencing pH, hydration levels, or lipid content, they can impact the microbial ecosystem. Although the microbiome demonstrates a certain degree of resilience, the precise and long-term effects of topical interventions remain only partially characterized (Grice & Segre, 2011; Santos et al., 2026).
Certain ingredients, such as harsh surfactants or broad-spectrum preservatives, may disrupt microbial balance. Their persistence on the skin surface prolongs their interaction with the barrier and can alter local ecological conditions. In addition, formulations combine multiple compounds that may interact with one another, making the assessment of their overall impact particularly complex (Santos et al., 2026).
Focused on preserving microbial balance, so-called “microbiome-friendly” cosmetics are gaining increasing attention within the industry. Their development is notably based on reducing, or even replacing, ingredients that may alter the skin microbiome.
When “more” becomes too much for the skin microbiome
The recent review by Santos et al. concludes:
“The delicate relationship between the host and its resident microorganisms highlights the critical demand for new topical products focused on balancing or not affecting the skin microbiome.” (Santos et al., 2026).
This perspective strongly aligns with the vision promoted by BYOME LABS: the goal of modern formulations should not be the systematic modulation of the skin microbiome.
A non-selective bactericidal effect can disrupt a healthy microbiome, just as excessive and untargeted stimulation may destabilize existing ecological balances, particularly when such modifications are applied repeatedly or without proper contextual consideration.
The challenge therefore lies in adopting a differentiated strategy: restoring balance in cases of dysbiosis or preserving stability when the microbiome is healthy. The objective is either to maintain equilibrium or to re-establish it, not to artificially stimulate a specific bacterial population at the risk of inducing dysbiosis.
In this context, the growing popularity of topical probiotics naturally raises questions about their relevance in the absence of imbalance. Although topical probiotics are increasingly available on the market, scientific evidence remains limited, with relatively few clinical studies rigorously assessing their efficacy (Habeebuddin et al., 2022).
The byome labs approach: personalization and contextualization
At BYOME LABS, we measure the impact of cosmetic, dermocosmetic, and pharmaceutical products on the skin, vaginal, oral, and scalp microbiomes.
We prioritize a collaborative approach with our clients to gain a precise understanding of their product, its positioning, its conditions of use, and the associated claims. This exchange phase is essential and is supported by an educational process aimed at identifying the most relevant tests considering the scientific and regulatory objectives of the project.
Within a preservation framework, we notably offer the Microbiome Respect program, dedicated to assessing the impact of formulations on a healthy skin microbiome. The objective is to verify that the product does not alter either the diversity or the functional balance of microbial communities, in line with current recommendations for so called microbiome friendly formulations.
At the same time, we also work on contexts of skin microbiome dysbiosis, such as acne or atopic dermatitis, where the challenge is no longer solely preservation but the restoration of an altered balance. BYOME LABS brings the same scientific rigor to each project, helping clients define whether the appropriate approach is preservation or restoration, and ensuring the generation of robust scientific evidence.

Sources
Borrego-Ruiz, A., & Borrego, J. J. (2024). Microbial Dysbiosis in the Skin Microbiome and Its Psychological Consequences. Microorganisms, 12(9), Article 9. https://doi.org/10.3390/microorganisms12091908
Grice, E. A., & Segre, J. A. (2011). The skin microbiome. Nature reviews. Microbiology, 9(4), 244‑253. https://doi.org/10.1038/nrmicro2537
Habeebuddin, M., Karnati, R. K., Shiroorkar, P. N., Nagaraja, S., Asdaq, S. M. B., Khalid Anwer, Md., & Fattepur, S. (2022). Topical Probiotics : More Than a Skin Deep. Pharmaceutics, 14(3), 557. https://doi.org/10.3390/pharmaceutics14030557
Santos, Y. R., Andréo-Filho, N., Lopes, P. S., & Leite-Silva, V. R. (2026). A review of skin microbiome and new challenges to cosmetic microbiome-friendly formulations. International Journal of Cosmetic Science. https://doi.org/10.1111/ics.70073
Suri, Hitakshika, Suri, Harshika, Nagda, N., Misra, T., & Vuppu, S. (2025). Current perspectives on the human skin microbiome : Functional insights and strategies for therapeutic modulation. Biomedicine & Pharmacotherapy, 193, 118655. https://doi.org/10.1016/j.biopha.2025.118655
CONTACT
info@byomelabs.com
www.byomelabs.com





